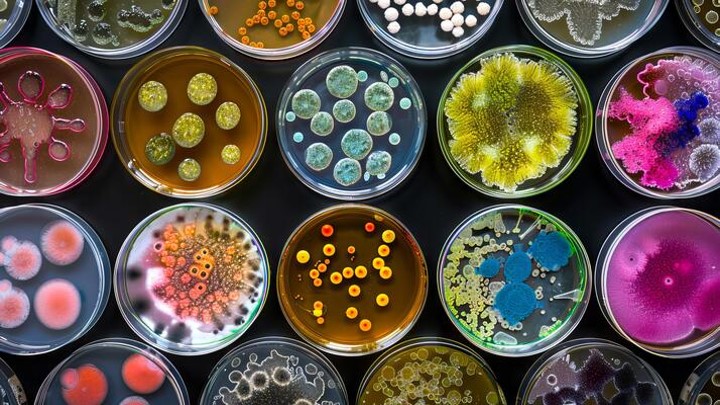

- المعلم: mouloud aitmechedal

Ce cours permettre à l'étudiant d'acquérir les éléments nécessaires à la compréhension de la structure moléculaire, des principales propriétés physico-chimique, ainsi que le métabolisme des acides aminés, et des acides nucléiques. Cet enseignement vise également à explorer les bases fondamentales de l'enzymologie.
- المعلم: mounira dehiri

- المعلم: samira labidi
- المعلم: dahbia tabti
Discovery Teaching Unit
Subject: General Ecology
Objective: The objective of this course is to help students understand the concept of an ecosystem, the abiotic and biotic factors and the interactions between these factors, the components of the ecosystem, and how it functions.
- المعلم: naima baaziz

La communication est un mécanisme de relations humaines (Charles Cooley).
C'est un échange verbal ou non verbal.
- المعلم: lynda loucif
Ce cours concerne les débutants (2 ieme année licence LMD science agronomiques) pour apprendre les bases de l'informatique à son propre rythme avec des cours sur la maîtrise des systèmes d'exploitation Windows, la bureautique, la protection de son ordinateur, des solutions de dépannage rapides en cas de blocage, des fiches pratiques sur différents sujets (usage du smartphone, fonctionnalités courantes avec un ordinateur).
- المعلم: toufik harizi
C’est l’étude des mécanismes qui régissent le fonctionnement et le développement des végétaux. Elle se divise en deux grandes parties :
1- Nutrition et métabolisme : qui se résument par
L’acquisition des éléments indispensables à la vie
La transformation de ces éléments et leur intégration dans la matière organique (dans la biomasse)
2- Croissance et développement : Mécanismes pour le passage de la graine de l’état de vie ralentie à l’état reproducteur (cycle de développement).
- المعلم: hizia kelaleche
This course focuses on fundamental concepts of the microbial world, including the basic characteristics of microorganisms. It introduces the main techniques used to observe microorganisms, as well as the principles of microbial growth and microbial classification.
- المعلم: tamine milouda
Ce cours est destiné à dispenser à l’étudiant les connaissances théoriques de base en microbiologie impliquant les notions du monde microbien, la morphologie cellulaire et les techniques utilisées pour observer les microorganismes, la nutrition et la croissance bactérienne, ainsi que des généralités sur la mycologie et la virologie. L’ensemble de ces connaissances sont ensuite mises en pratique au niveau du laboratoire.
- المعلم: nouari sadrati
